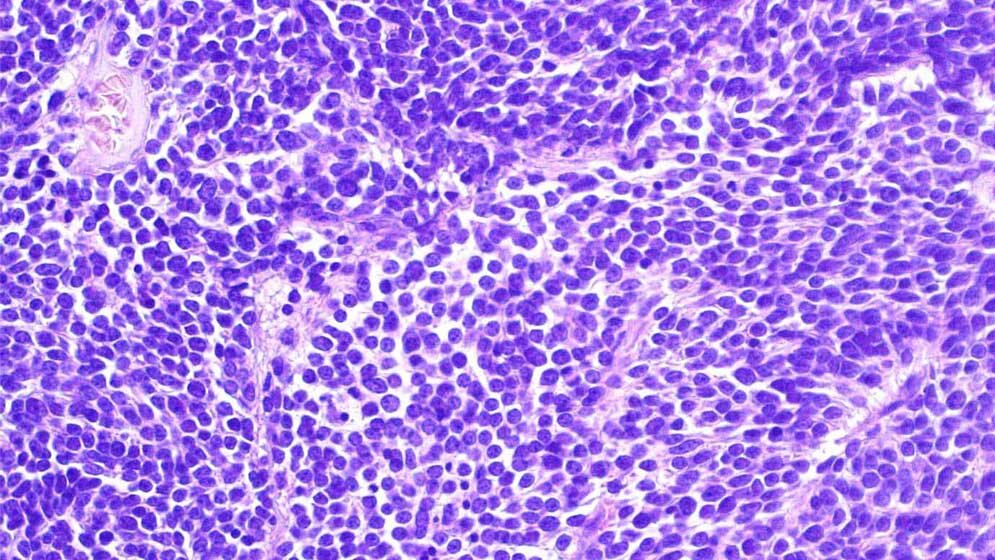
Diagnose_neuroektodermaler_Tumor_des_Zentralnervensystems_Dominik_Sturm__KiTZ.jpg Diagnose „neuroektodermaler Tumor des Zentralnervensystems“

Die Wissenschaftler konnten in der vom Deutschen Krebskonsortium (DKTK) unterstützten klinischen Studie zeigen, wie wichtig es sowohl für die Diagnosestellung und die Wahl der richtigen Behandlungsstrategie ist, die molekularen Eigenschaften der Tumoren zu kennen. Das Hopp-Kindertumorzentrum Heidelberg (KiTZ) ist eine gemeinsame Einrichtung des Deutschen Krebsforschungszentrums (DKFZ), des Universitätsklinikums Heidelberg und der Universität Heidelberg.
Unterschiede berücksichtigen
Oft unterscheiden sich mikroskopisch ähnliche Hirntumoren auf molekularer Ebene stark voneinander – Unterschiede, die bei der Wahl des Behandlungsverfahrens berücksichtigt werden müssen. Kinder, die an embryonalen Hirntumoren erkrankt sind, müssen meist besonders intensive, beschwerliche Therapien durchlaufen. Sie haben – abhängig von ihrer Tumoruntergruppe – oft dennoch nur geringe Heilungschancen. Das trifft auch für die sogenannten „supratentoriellen primitiven neuroektodermalen Tumoren“ (sPNETs) zu: Diese Krebsformen gehen aus unreifen Zellen des Zentralnervensystems (ZNS) hervor und wachsen daher besonders schnell und aggressiv.
sPNET mit modernen Datenanalysemethoden untersucht
Das Team um Professor Stefan Pfister, KiTZ Direktor, Abteilungsleiter „Pädiatrische Neuroonkologie“ am DKFZ und Oberarzt am Universitätsklinikum Heidelberg untersuchte zusammen mit Kollegen des Fred Hutchinson Cancer Research Center (Seattle, USA) und des Children’s National (Washington DC, USA) sPNET mit modernen Datenanalysemethoden. Dazu nahmen die Wissenschaftler im Tumorgewebe von Patienten, die an einer Phase-III-Studie für mikroskopisch diagnostizierte sPNETs teilnahmen, bestimmte chemische Markierungen des Erbguts, sogenannte DNA-Methylierungen unter die Lupe. Mit diesem Verfahren konnten sie Tumoruntergruppen unterscheiden, die sich durch eine reine mikroskopische Analyse nicht voneinander trennen ließen.
Vielen Kindern eine belastende Behandlung ersparen?
Würde diese molekular-diagnostische Klassifizierung routinemäßig vor der Behandlung eingesetzt, könnte vielen Kindern eine belastende Behandlung erspart werden. Davon ist Pfister, einer der Hauptautoren der Studie, überzeugt. „Bei den meisten Kindern mit ZNS-Tumoren ist eine genaue Diagnose und damit auch Abschätzung der Prognose möglich, wenn neben den histologischen Untersuchungen eine Methylierungsanalyse des Tumor-Erbguts durchgeführt wird“, erklärt er. „Wir können so besser beurteilen, wem eine intensive Bestrahlungs- und Chemotherapie mit hoher Wahrscheinlichkeit nutzen kann, und wenn ja welche. Dadurch können wir so manchem Kind unnötige Therapieelemente ersparen.“
Einige „Falschklassifizierte“ entdeckt
Im speziellen Fall der vorliegenden Studie stellte sich durch die Methylierungsuntersuchung heraus, dass nur wenige Patienten tatsächlich ein sPNET hatten und ein erheblicher Teil stattdessen biologisch eindeutig ein sogenanntes kleinzelliges Glioblastom. Auch Ependymome und andere seltenere Tumorarten verbargen sich im Sammelsurium von mikroskopisch als sPNET diagnostizierten Tumoren. Wenn man diese „Falschklassifizierten“ herausrechnet, ist bei sPNET die Prognose deutlich besser als seit Jahrzehnten angenommen und die Patienten sprechen mit größerer Wahrscheinlichkeit auf die Chemotherapie an.
Da die molekulare Charakterisierung embryonaler kindlicher Krebserkrankungen des zentralen Nervensystems zu Beginn einer Behandlung entscheidenden Einfluss auf die Art und den Erfolg der Therapie nehmen kann, empfehlen die Wissenschaftler, sie als Standardverfahren in die Diagnosestellung einzubeziehen. (DKFZ, red)
Hwang, et al. 2018: Extensive Molecular and Clinical Heterogeneity in Patients With Histologically Diagnosed CNS-PNET Treated as a Single Entity: A Report From the Children’s Oncology Group Randomized ACNS0332 Trial. DOI: 10.1200/JCO.2017.76.4720. Journal of Clinical Oncology – Online-Publikation am 17. Oktober 2018.
Artikel teilen